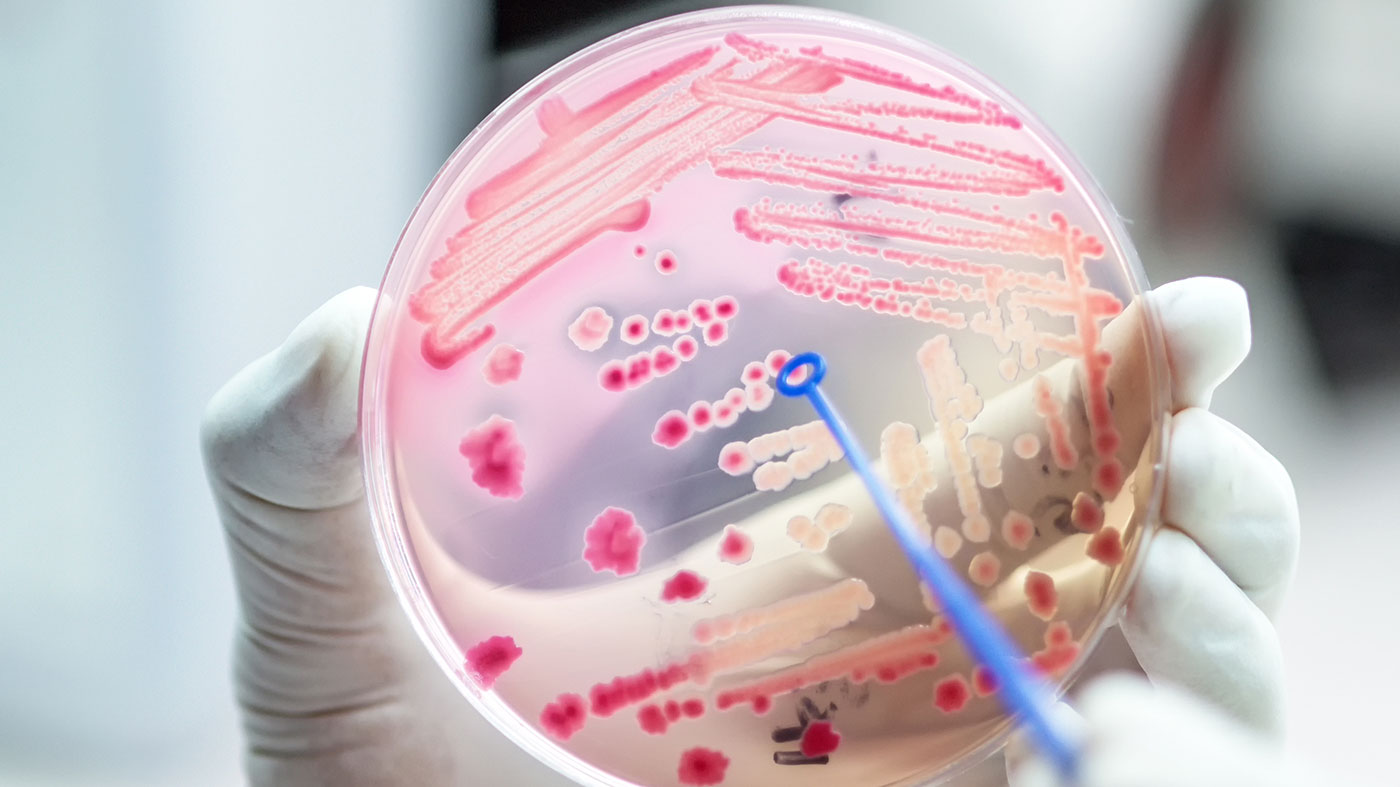

Antibiotic resistance in veterinary medicine
Written and edited by Nida Fatima, MD and Jakob Bower.
Resistance to antibiotics is one of the most common and life-threatening issues for animals and humans worldwide. Recently, this resistance has been considered a key feature of ‘modern’ microbes, resulting from either unsuccessful and/or prolonged exposure to antimicrobial treatments.
Antibiotic-resistant microbes originating in pets are responsible for both direct and indirect threats on human health, such as methicillin-resistant staphylococcus aureus, vancomycin-resistant enterococci, carbapenemase-producing enterobacteria, and extended spectrum beta-lactamase gram-negative bacteria 1.
More information regarding intrinsic antibiotic resistance can be found here.
The Centers for Disease Control and Prevention (CDC) further describes the issue of antibiotic resistance spread to humans.
Certain restrictive measures have been adopted in the veterinary field which include banning antibiotics for growth-promoting purposes, developing immunization programs, and increasing the traceability of antibiotic prescriptions 2.
However, there still needs to be a joint intervention between all sectors and a worldwide effort in the acquisition and enforcement of regulatory measures 2. Appropriate legislative measures must be taken to guarantee fair behavior and ensure public health.
References:
- Pomba C., Rantala M., Greko C., Baptiste K.E., Catry B., van Duijkeren E., Mateus A., Moreno M.A., Pyörälä S., Ružauskas M., et al. Public health risk of antimicrobial resistance transfer from companion animals. J. Antimicrob. Chemother. 2017;72:957–968. doi: 10.1093/jac/dkw481
- Palma E, Tilocca B, Roncada P. Antimicrobial Resistance in Veterinary Medicine: An Overview. Int J Mol Sci. 2020;21(6):1914. Published 2020 Mar 11. doi:10.3390/ijms21061914